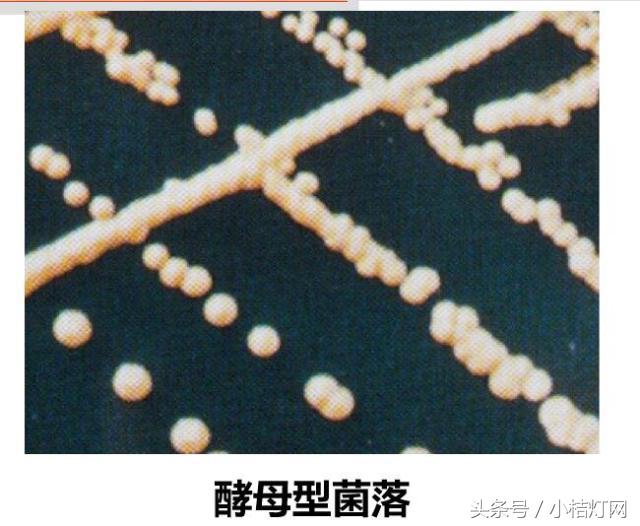
真菌微生物国标检测方法,微生物真菌检验

编者按:
本次章节新增篇章,为真菌分篇篇章。包含了:真菌相关的知识点。
关键词:医学真菌。
其意义在于概括了真菌概论。
一
真菌概述
节选《真菌性皮肤病》
上海交通大学医学院
真菌
真菌(fungus):是一类具有细胞壁和典型细胞核结构,缺乏叶绿素,不分根、茎、叶,能进行无性或有性繁殖的真核细胞型微生物。
胞壁不含肽聚糖,故不受青霉素、头孢菌素的影响;胞膜含固醇对二性霉素B、制霉菌素(与固醇结合)、酮康唑(抑制固醇合成)敏感。

组成:核膜和核仁(细胞核)
完整的细胞器(胞浆)
单细胞(少数)或多细胞(多数)
生存方式:腐生或寄生
繁殖方式:有性或无性
多数对人类有益,少数有害
分布广泛、种类繁多
少数有害:医学(病原)真菌400种,常见的有50~100种。

目前真菌病呈明显上升趋势:
1.抗生素、抗肿瘤药物、免疫*制剂抑**等的滥用
2.器官移植、介入性治疗等新型技术的开展
3.艾滋病、糖尿病、恶性肿瘤等疾病造成宿主免疫功能低下
二
真菌分类


形态:多种多样
有典型的核结构和细胞器
按形态、结构分为两类:
单细胞真菌
多细胞真菌

单细胞真菌
圆形或椭圆形
包括:酵母型真菌:无菌丝,母细胞以芽生方式繁殖,菌落与细菌的菌落相似。
类酵母型真菌:母细胞以芽生方式繁殖,出芽产生的芽生孢子持续延长,但不断裂、不与母细胞脱离,产生相互连接成藕节状较长的细胞链,可伸入培养基内,称假菌丝 。

多细胞真菌
基本结构:菌丝和孢子
菌丝(hypha):孢子生出嫩芽,称为芽管管逐渐延长呈丝状,称为菌丝。
孢子(spore):真菌的生殖结构,由生殖菌丝产生。
菌丝体(mycelium):菌丝交织成团。
根据功能不同分为:
营养菌丝(vegetative mycelium)
气生菌丝(aerial mycelium)
生殖菌丝(reproductive mycelium)
根据隔膜的消长分为:
有隔菌丝(大部分病原性丝状菌)
无隔菌丝

根据形态不同分为:
单纯菌丝
球拍状菌丝
破梳状菌丝
螺旋状菌丝
结节状菌丝
鹿角状菌丝等

孢 子
生殖结构,由生殖菌丝产生,是鉴定和分类的主要依据。
无性孢子
不经两性细胞配合而产生的孢子。病原性真菌大多数产生无性孢子。
o叶状孢子(thallospore)
芽生孢子(blastospore)
关节孢子(arthrospore)
厚膜孢子(chlamydospore)
o分生孢子 (conidia)
大分生孢子(macroconidia)
小分生孢子(microconidia)
o孢子囊孢子(sporangiospore)
有性孢子
细胞间配合(质配和核配)后产生,绝大多数为非致病性真菌所具有。
o接合孢子
o子囊孢子
o担(子)孢子

三
真菌的繁殖与培养
依靠孢子及菌丝进行繁殖
繁殖方式:
无性繁殖——真菌的主要繁殖方式
有性繁殖
无性繁殖主要包括:
芽生 母细胞发芽产生。常见于酵母型和类酵母型真菌。
裂殖 母细胞二分裂产生。如裂殖酵母。
芽管 萌发芽管,伸延形成菌丝。
隔殖 分生孢子梗形成一隔膜,原生质浓缩形成新孢子。
培养特性
培养基:营养要求不高,常用沙氏葡萄糖琼脂培养基(SDA)、马铃薯葡萄糖琼脂培养基(PDA)、察氏培养基(Czapek-Dox Agar)、脑心浸膏琼脂培养基(BHI)
温度:
37℃(酵母型和类酵母型真菌)
25~28℃(丝状真菌)
最适pH:4.0~6.0
生长速度:多数病原性真菌生长缓慢






四
菌落
1.酵母型菌落
芽生孢子,无菌丝。如新生隐球菌
2.类酵母型菌落(酵母样菌落)
呈藕节状细胞链的假菌丝。
如白假丝酵母

3.丝状型菌落
菌落形态和颜色可作为鉴定、分类的参考依据。见于大多数丝状真菌

o变异性
形态、结构、及生理性状(毒力)等。
o抵抗力
对热抵抗性不强(孢子60℃经1 h即杀灭)耐受:干燥、紫外线及多种化学药物等敏感:1% ~3%石炭酸、2.5%碘酊及10%甲醛液。

五
真菌感染
真菌感染
o原发性感染:
致病性真菌
球孢子菌(coccidiodes)
皮炎芽生菌(blastomyoes dermatitidis)
组织胞浆菌(histoplasma)
马尔尼菲青霉(penicillium marneffei)等
o继发性感染:
机会致病性真菌
机体免疫功能显著下降时发生
真菌性超敏反应
按性质分类:
感染性超敏反应: 感染,Ⅳ型
接触性超敏反应: 吸入或食入,Ⅰ~Ⅳ型
按部位分类:
皮肤超敏反应
呼吸道超敏反应
消化道超敏反应
真菌毒素中毒
o来源:真菌代谢产生毒素,存在于农作物、食物或饲料中
o表现:
1. 肝、肾、神经、造血系统等损伤
2. 致癌(黄曲霉毒素等)
真菌免疫性
o非特异性免疫
1.皮肤粘膜屏障作用
2.正常菌群拮抗作用(白假丝酵母菌)
3.吞噬作用
o特异性免疫
1.细胞免疫
2.体液免疫
六
真菌实验室检查
实验室检查
1.样本采集:
o浅部:鳞屑、病发或甲屑
o深部:痰、脓、血、尿、便、脑脊液、胸水及分泌物等
o注意:标本应足量、新鲜严格无菌操作资料应齐全
2.形态学检查:
o直接镜检:
标本处理(10%KOH)
涂片染色(革兰染色、墨汁染色)
o分离培养:
含抗生素和放线菌酮的SDA、PDA
酵母型和类酵母型真菌: 37℃,革兰染色
丝状真菌:25℃,乳酸酚棉兰染色
3.血清学检测:
真菌抗原、代谢产物及机体产生的抗体
o抗原:1,3-β-D-葡聚糖(G试验)
甘露聚糖(EIA法或FACE)
半乳甘露聚糖(GM试验)
隐球菌荚膜多糖(乳胶凝聚试验)
o抗体:甘露聚糖抗体(凝胶对流电泳)
烯醇化酶抗体(凝集试验)
马尔尼菲青霉抗体(ELISA法)
o代谢产物:
D-阿拉伯糖醇(酶荧光法)
烯醇化酶(斑点印迹法或DFA)
4.核酸检测:
o核酸G+C mol%测定
oPCR相关技术:巢氏PCR、复合PCR、荧光PCR等
oDNA指纹技术:RFLP、DGGE、SSCP等
o核酸杂交:原位杂交、RDB、基因芯片技术等
oDNA特殊序列分析:ITS、LSU、TEF、线粒体cyt b、COⅠ和COⅡ、b-微管蛋白等基因

5.抗真菌药物
o皮肤癣菌:
注意清洁卫生,避免接触,局部使用特比萘芬、酮康唑、咪康唑或克霉唑
o深部真菌病:
去除各种诱因,提高抵抗力,常用氟康唑、伊曲康唑、伏立康唑、两性霉素B、5-氟胞嘧啶、卡泊芬净、米卡芬净等
o真菌性食物中毒:严禁食用发霉食品